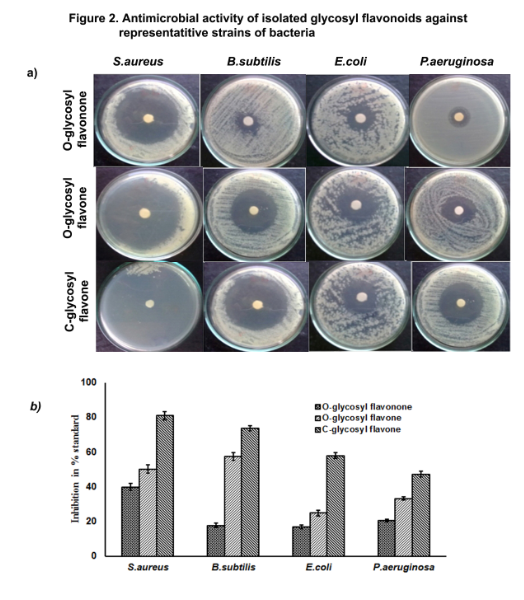

Int J Pharm Pharm Sci, Vol 8, Issue 5, 296-305Original Article
EFFECT OF C-GLYCOSYL FLAVONE FROM URGINEA INDICA ON ANTIBIOTIC INDUCED MICROBIAL CELL DEATH
BEVARA GANESH BABUa, A. D. NAVEEN KUMARa, ANIL BADANAa, SEEMA KUMARIa, ANJALI JHAb, RR MALLAa*
aCancer Biology Lab, Department of Biochemistry, GITAM University, Visakhapatnam, Andhra Pradesh, India 530045, bDepartment of Chemistry, GITAM University, Visakhapatnam, Andhra Pradesh, India 530045
Email: dr.rrmall@gmail.com
Received: 12 Feb 2016 Revised and Accepted: 30 Mar 2016
ABSTRACT
Objective: The aim of the present study was to isolate and characterize C-glycosyl flavone from Urgenia. indica bulb and to evaluate its effect on microbial cell growth.
Methods: Methanolic extract of U. indica bulb was prepared using Soxhlation. Isolation was performed using silica gel column chromatography, and characterization was done based on IR, NMR and mass spectral data. The effect of C-glycosyl flavone was evaluated on microbial growth inhibition C-glycosyl flavone in terms of cytotoxicity, cell membrane damage, and cell death.
Results: The results indicates that O-glycosyl flavanone (5,41-di hydroxyl-31-methoxy-7-O-[(α-L-rhamnosyl-(1[11]1-6[11])-β-D-glucopyranosyl)] flavanone), O-glycosyl flavone (5,41-dihydroxy-31-methoxy-7-O-β-D-glucopyranosyl flavone) and C-glycosyl flavone (5,7-dihydroxy-2-[41-hydroxy-31-(methoxymethyl) phenyl]-6-C-β-glucopyranosyl flavones) showed significantly sensitivity against Staphylococcus aureus, Bacillus subtilis, Rhizopus oryzae and Aspergillus niger. Synergism of C-glycosyl flavone on antibacterial activity of ciprofloxacin with the FIC index of 0.3 against S. aureus and 0.5 against B. subtilis. Antifungal activity of clotrimazole with the FIC index 0.3 against R. oryzae and 0.48 against A. niger. C-glycosyl flavone increased the ciprofloxacin-induced cytotoxicity from 63 to 91% against S. aureus and 56 to 89% against B. subtilis, whereas clotrimazole is induced cytotoxicity from 36 to 49% against R. oryzae and 23 to 41% against A. niger. C-glycosyl flavone increased the ciprofloxacin-induced cell death in S. aureus and B. subtilis and clotrimazole induced cell death in R. oryzae and A. niger as evident by propidium iodide staining, Tunel positive cells, and cytoplasmic membrane damage.
Conclusion: The present investigation provides scientific and rationalism for the folkloric use of U. indica as an antimicrobial agent.
Keywords: Antimicrobial, Synergism, Cytotoxicity, Cytoplasmic membrane damage and cell death
© 2016 The Authors. Published by Innovare Academic Sciences Pvt Ltd. This is an open access article under the CC BY license (http://creativecommons.org/licenses/by/4.0/)
INTRODUCTION
Studies in the recent past have reported that diseases and disease-causing agents were recurring in new forms and resistant to existing antibiotics [1]. The emergence of multi-drug resistant microbial strains is limiting the effectiveness of current drugs and significantly causing treatment failure of infections [2]. To face such a challenge, there is a need to develop an alternative, approaches that can enhance the efficacy of antibiotics to target resistance.
Combination therapy has been shown to be beneficial for drug-resistant infectious diseases which do not normally respond to single-drug therapy. Studies have demonstrated that the natural products enhanced the action of antibiotics against multidrug resistant microorganisms [3-4]. However, the mechanism of action of natural products on antibiotic-induced microbial death remains largely unknown.
Programmed cell death (PCD) is a genetically controlled process associated with development and homeostasis of bacteria, fungi, plants and animals [5]. E. coli exhibited apoptotic markers such as exposure of phosphatidylserine, condensation of chromosomes and DNA fragmentation with antibiotic treatment [6]. R. oryzae cells treated with triazoles in combination with hyperthermia (42 °C) exhibited characteristic markers of early apoptosis such as externalization of phosphatidylserine, fragmentation, and condensation of DNA, membrane depolarization and increased metacaspase activity [7]. An apoptosis-like process similar to eukaryotes with activation of a caspase-3-like protease (C3LP) followed by DNA fragmentation was reported in B. subtilis [8]. A more recent study by Anandhi et al., (2014)[11] demonstrated marked DNA fragmentation in E. coli and S. aureus with glycosides and flavonoids [9]. PCD has been proposed as a potential target for new antibacterial therapy [10].
Flavonoids reported having good antibacterial potential with bacteriostatic activities against different Gram-negative bacteria such as E. coli and P. aeruginosa. They also possess an inhibitory effect on S. aureus and on the growth of spore-forming B. subtilis [11]. Flavonoids also reported having synergistic behavior in combination with other flavonoids and antimicrobial agents [12]. Earlier reports claimed that the natural compounds like alkyl gallates and gallic acid with different classes of β-lactams antibiotics showed maximum inhibitory activity in clinical isolates [13].
The antibiotic additive and synergistic action of flavonoids against methicillin-resistant S. aureus. C-glycosyl flavone are a class of glycosylated flavonoids with good health benefits. Tatsuya Hasegawa et al., (2008) [14] reported that C-glycosyl flavone exhibits stronger radical scavenging activity than ascorbic acid [15]. The C-glycosyl flavonoids showed higher antioxidant potential than their corresponding O-glycosyl flavonoids and aglycones [11].
Urginea indica is a rare, endangered and threatened medicinal plant belongs to Liliace family and commonly called as sea onion. Its bulbs are used to cure wound and infections [16]. Recently, antioxidant [17] and antibacterial activities of crude extracts from U. indica bulb were evaluated. However, antimicrobial efficacy and synergistic effect of purified glycosyl flavonoids from U. indica were not reported. In this study, one novel glycosyl flavonoid together with two known compounds was isolated from U. indica bulb. Synergistic antimicrobial efficacy isolated glycosyl flavonoids together with known antibiotics was evaluated against pathogenic microorganisms, E. coli, P. aeruginosa, S. aureus, B. subtilis, R. oyzae and A. niger. Further, the mode of synergistic action of C-glycosyl flavone on ciprofloxacin-induced cell death in S. aureus and B. subtilis or clotrimazole in R. oryzae and A. niger.
MATERIALS AND METHODS
Chemical and solvents
Silica gel, methanol, ethyl acetate, potato dextrose agar, Muller Hinton broth, acetonitrile (HPCL grade) were obtained from Merck, India.
Microorganisms and antibiotics
S. aureus, B. subtilis, E. coli, P. aeruginosa, A. niger and R. oryzae were obtained from MTCC, Chandigarh. Ciprofloxacin and clotrimazole were obtained from HiMedia (Mumbai, India).
Preparation of extracts
The U. indica (red variety) bulbs were collected from the Eastern Ghats of Vizianagaram district and authenticated by Botanical Survey of India, Hyderabad, India (No. BSI/DRC/2013-14/ Tech/802).Methanolic extract was prepared from shade dried bulbs using Soxhlation for 48h. The extract was evaporated to dryness under reduced pressure at 40 °C.
Isolation and characterization of C-glycosyl flavonoids
Silica gel column chromatography was performed for isolation of glycosyl flavonoids from the methanolic extract of defatted powder of U. indica bulb. The sample was loaded, eluted with a gradient system of methanol and ethyl acetate mixture, beginning from 5:95, 10:90, 15:85, 20:80, 25:75, 30:70, 35:65, 40:60, 45:55, 50:50, 55:45, 60:40, 65:35, 70:30, 75:25, 80:20, 85:15, 90:10, 95:5 ratio and finally with 100% methanol. The homogeneity of fractions was analyzed using silica gel G pre-coated thin layer chromatography with different ratios of methanol and ethyl acetate as mobile phase. The spots were developed by spraying with 20% H2SO4 in methanol and subsequent heating for 5 min at 110°C. The purity of fractions was analyzed by HPLC with C18 column (250 X 4.60 mm) using acetonitrile: water: formic acid (60:40:1) mixture as mobile phase at a flow rate of 0.5 ml/min. The phenolic nature of isolated compounds was identified by preliminary phytochemical and UV-Visible spectral analysis. The structure was elucidated based on IR, NMR and Mass spectral data.
Antimicrobial assays
Bacterial suspensions were prepared from log phase cultures as per Mc Farland standard (108 CFU/ml) [18]. Antibacterial activity of glycosyl flavonoids was determined by agar well diffusion method. Glycosyl flavonoids (5-25µg/ml) or 25µg/ml were added to each well aseptically, and plates were incubated at 37° C for 24 h. Ciprofloxacin, erythromycin, rifampicin, streptomycin at the concentration ranging from 2-10µg/ml or ciprofloxacin 10µg/ml was used as standard (10µg/ml). A zone of inhibition (mm) was measured using HiMedia zone inhibition scale and percent antibacterial activity was expressed with reference to standard [19].
Antifungal activity of glycosyl flavonoids (5-25µg/ml) or 25µg/ml was determined against A. niger and R. oryzae using mycelial growth reduction assay [20] with PDA medium. PDA plate without glycosyl flavonoids was served as control. Clotrimazole concentrations from 2-10µg/ml or 10µg/ml were used as the standard. The linear growth of fungi was measured in cm after 7days incubation at 28±2 °C and % of linear growth reduction was calculated using the Formula: Growth in control plate-Growth in treatment plate x 100/Growth in control plate.
Minimum inhibitory concentration (MIC)
In 96-well plate, 50 μl of Mueller–Hinton broth for bacteria or Potato dextrose broth for fungi was taken, and 50 μl of glycosyl flavonoid (25µg/ml) were added to the first row of the plate. Then, serial dilutions were performed (1/2, 1/4, 1/8, 1/16, 1/32 and 1/64) up to 64 folds to reduce the concentration from 25 to 0.3 µg/ml and then 20 μl of inoculum was added to each well. Standard antibiotic at 10, 5, 2.5, 1.25, 0.6, 0.3 µg/ml was used as positive control. Wells without glycosyl flavonoids was served as negative control. The plates were incubated for 18 h at 37°C and 72h at 29 °C for bacteria and fungi, respectively. After incubation, 50 μl of 2, 3, 5-triphenyl tetrazolium chloride (TTC) solution (0.01%) was added to each well and again incubated for 1h. Least concentration of glycosyl flavonoids, which showing no color change was considered as MIC [21].
Minimum bactericidal and fungicidal concentration (MBC and MFC)
MBC and MFC of glycosyl flavonoids were determined using standard protocols [22]. Agar blocks from the plates that showed no growth in MIC test was transferred to a corresponding broth and incubated at 32 °C for 24h (bacteria) or 29 °C for 72h (fungi). Finally, the growth of bacteria was determined by turbidimetry and fungi by hemocytometer. Bactericidal or bacteriostatic nature of glycosyl flavonoids and standards were determined using MIC index.
Checkerboard broth dilution method
The synergistic effect of glycosyl flavonoids on standard antibiotics was evaluated by checkerboard broth dilution method [23]. The synergistic effect of glycosyl flavonoids on microorganism was calculated from fractional inhibitory concentration (FIC) index using the formula: MIC of glycosyl flavonoid in combination/MIC of glycosyl flavonoid alone+MIC of antibiotic in combination/MIC of antibiotic alone.
Determination of cytotoxic activity by MTT assay
3-(4,5-Dimethylthiazol-2-yl)-2,5-Diphenyltetrazolium Bromide (MTT) assay was used to evaluate the synergistic effect of C-glycosyl flavone on antibiotic-induced cytotoxicity against test microorganisms [24]. Nutrient broth containing bacteria (107 CFU/100 µl) or Potato dextrose broth containing fungi (1x108 cells/100 µl) was added to each well of the 96-well plate. S. aureus and B. subtilis were treated with C-glycosyl flavone at 1.56 and 0.75 µg/ml, respectively or ciprofloxacin at 0.6 and 1.25 µg/ml, respectively or combination in a final volume of 150 µl and incubated for 24 h. R. oryzae and A. niger were treated with C-glycosyl flavone at 0.75 and 1.56 µg/ml, respectively, or clotrimazole at 0.62 and 1.25 µg/ml, respectively or combination in a final volume of 150 µl and incubated for 24 h. Untreated wells were served as controls. After treatment, 20 µl MTT solutions (5 mg/ml in PBS) was added and incubated at 37 °C for 2h. Then 100 µl of dimethyl sulfoxide (DMSO) was added to each well to develop color. After 30 min of incubation, the absorbance (OD) was measured using an ELISA reader at a wavelength of 492 nm and cytotoxicity was expressed as percent control.
Determination of cell death by propidium iodide staining
Propidium iodide staining assay was used to evaluate the synergistic effect of C-glycosyl flavone on antibiotic-induced cell death in bacteria [24]. S. aureus, B. subtilis, R. oryzae and A. niger were treated with C-glycosyl flavone in 0.75 and 1.56 µg/ml, respectively, or clotrimazole at 0.62 and 1.25 µg/ml, respectively, or combination for 24h as described above. Untreated wells were served as controls. After treatment, 50 µl of propidium iodide solution (15 µM) was added to each well and incubated in the dark at room temperature for 10 min. The treated and untreated samples were filtered through black Millipore polycarbonate filters. The filters were rinsed with sterile distilled water to remove the unincorporated stain. PI positive cells on filters were counted within 1 h under the fluorescent microscope and expressed as percent control.
TUNEL assay
S. aureus, B. subtilis, R. oryzae and A. niger were treated with C-glycosyl flavone at 0.75 and 1.56 µg/ml, respectively or clotrimazole at 0.62 and 1.25 µg/ml, respectively, or combination for 24h as described above. Untreated wells were served as controls. The hydroxyl group of the DNA fragments in cells was labeled and stained by terminal deoxynucleotidyl transferase (TdT)-mediated dUTP nick end labeling method using an apoptosis in situ detection kit (Roche, USA), according to the manufacturer's instructions. The cell nucleus was labeled by 4',6-diamidino-2-phenylindole (DAPI) (Invitrogen, USA) and the nick-ends were labeled in green. The treated and untreated samples were filtered through black Millipore polycarbonate filters. Positively fluorescein-labeled cells were visualized with the fluorescence microscopy, quantified, and expressed as percent compared to DAPI stained cells [24].
Detection of cytoplasmic membrane damage
The assessment of the potassium present in the medium was carried out using flame photometer at a wavelength of 766.480 nm. The instrument was calibrated using standard solutions containing 0.05, 0.1, 0.5, 1.0 and 5.0 μg/ml potassium chloride in ultra-pure deionized water. Aliquots of 100 μl from test microorganisms were separately incubated overnight. The rise in the amount of potassium in the supernatant, caused by antibiotic alone or C-glycosyl flavone alone or C-glycosyl flavone-antibiotics combination was measured following separation of cellular debris by centrifugation at 4000 rpm [11].
Statistical analysis
All experiments were carried out in triplicates, and the data was expressed as mean±SD.
RESULTS
Medicinal plants have been contributed traditionally to human health. Studies have reported that the medicinal plants are potential sources of antimicrobial agents [9] and also natural compounds can enhance the antimicrobial efficacy of antibiotics [5].
Isolation and characterization of C-glycosyl flavone
Medicinal plants have been contributed traditionally to human health and are a potential source of therapeutic agents and also lead to the antibiotics. Elution of silica gel column containing crude methanolic extract of U. indica bulb with methanol: ethyl acetate solvent gradient system resulted in the isolation of three homogeneously pure compounds (fig. 1a).

Fig. 1: Molecular structures of isolated flavonoids (a) O-glycosyl flavanone, (b) O-glycosyl flavone and (3) C-glycosyl flavone
The phenolic nature of isolated compounds was identified by preliminary phytochemical and UV-Visible spectral analysis (Data not shown). The structure of isolated compound-1 was elucidated as 5, 7-dihydroxy-2-[4'-hydroxy-3'-(methoxy-methyl) phenyl]-6-O-β-glucopyranosyl flavone (O-glycosyl flavanone: C23H24 011) based on UV (MeOH) λmax nm: 271. IR (KBr) νmax cm−1: 3386, 2923, 2852, 1715, 1515, 1454, 1383, 1074, 910. ESI-MS (C23H24O11) m/z: 493. 1H NMR (300 MHz, DMSO-d6): δ ppm 13.10 (1H, s, OH-5), 9.00 (1H, s, OH-4), 5.45 (1H, dd, J = 6.1, 9.1 Hz, H-2) 1.85 (1H, dd, J = 12.1 Hz, H-3a), 3.15 (1H, dd, J = 11.0, 16.3 Hz, H-3b), 2.13 (1H, d, J = 2.3 Hz, H-6), 1.31 (1H, d, J = 1.7 Hz, H-8), 8.05 (1H, s,OH-7), 7.4 (1H, d, J = 7.4 Hz, H-8), 7.42 (1H, d, J = 3.4 Hz, H-6’), 4.21 (5H, s, sugar), 3.12 (2H, s, CH2-1’’’), 3.78 (3H, s, OCH3). 13C NMR (600 MHz, DMSO-d6) δ ppm 151.7 (C-2), 101.39 (C-3), 178.51 (C-4), 160.79 (C-5), 166.41 (C-7), 108.44 (C-4a), 162.69 (C-8a), 71.12 (C-1″), 64.49 to 82 (C-2″-C-5″), 30.85 (C-6″), 57.2 (OCH3).
However, the structure of isolated compound-2 solved as 5, 4'-dihydroxy-3'-methoxy-7-O-β-D-glucopyranosyl flavone (O-glycosyl flavone: C22H24O11) based on: UV (MeOH) λ max nm: 348. IR (KBr) νmax cm−1: 3424, 2924, 1642, 1536, 1502, 1384, 1025, 1000, 974. ESI-MS (C22H24O11) m/z: 464 [M]+. 1H NMR (300 MHz, DMSO-d6): δ ppm 11.91 (1H, s, OH-5), 7.89 (1H, s, OH-4), 5.67 (1H, dd, J = 6.1, 9.0 Hz, H-2) 1.25 (1H, dd, J = 10.4 Hz, H-3a), 3.01 (1H, dd, J = 11.0, 15.2 Hz, H-3b), 6.11 (1H, d, J = 2.1 Hz, H-6), 6.16 (1H, d, J = 2.4 Hz, H-8), 6.82 (1H, dd, J = 2.9, 7.0 Hz, H-20), 6.99 (1H, d, J = 8.0 Hz, H-30), 6.90 (1H, d, J = 3.3 Hz, H-6), 5.67 (1H, d, J = 7.3 Hz, H-1″), 3.32-3.72 (5H, sugar), 3.66 (3H, OCH3). [13]C NMR (600 MHz, DMSO-d6): δ ppm 79.56 (C-2), 39.62 (C-3), 187.39 (C-4), 98.3 (C-6), 96.51 (C-8), 130.37 (C-10), 113.1 (C-20), 118.43 (C-30), 70 to 75 (C-2″-C-5″), 68.52 (C-6″), 56.05 (OCH3).
On the other hands the structure of compound-3 was resolved as 5, 7-dihydroxy-2-[4'-hydroxy-3'-(methoxymethyl) phenyl]-6-C-β-glucopyranosyl flavone (C-glycosyl flavone:C23H24 011) based on UV (MeOH) λmax nm: 271. IR (KBr) νmax cm−1: 3386, 2923, 2852, 1715, 1515, 1454, 1383, 1074, 910. ESI-MS (C23H24O11) m/z: 493. 1H NMR (300 MHz, DMSO-d6): δ ppm 13.10 (1H, s, OH-5), 9.00 (1H, s, OH-4), 5.45 (1H, dd, J = 6.1, 9.1 Hz, H-2) 1.85 (1H, dd, J = 12.1 Hz, H-3a), 3.15 (1H, dd, J = 11.0, 16.3 Hz, H-3b), 2.13 (1H, d, J = 2.3 Hz, H-6), 1.31 (1H, d, J = 1.7 Hz, H-8), 8.05 (1H, s,OH-7), 7.4 (1H, d, J = 7.4 Hz, H-8), 7.42 (1H, d, J = 3.4 Hz, H-6’), 4.21 (5H, s, sugar), 3.12 (2H, s, CH2-1’’’), 3.78 (3H, s, OCH3). 13C NMR (600 MHz, DMSO-d6) δ ppm 151.7 (C-2), 101.39 (C-3), 178.51 (C-4), 160.79 (C-5), 166.41 (C-7), 108.44 (C-4a), 162.69 (C-8a), 71.12 (C-1″), 64.49 to 82 (C-2″-C-5″), 30.85 (C-6″), 57.2 (OCH3).
Effect of Isolated glycosyl flavonoids on microbial growth
As a preliminary study, the antimicrobial activity of isolated glycosyl flavonoids was evaluated as described earlier [25] at different concentrations ranging from 5-25µg/ml and results were expressed as a zone of inhibition in mm (table 1). A significantly high zone of inhibition was observed with isolated glycosyl flavonoids at 25µg/ml (Fig.2a). Antimicrobial activity of ciprofloxacin, erythromycin, rifampicin and streptomycin was evaluated at concentrations ranging from 2-10µg/ml to select a potential standard antibiotic for synergistic study (table 2). However, the significantly high zone of inhibition was observed with standard antibiotic ciprofloxacin at 10µg/ml compared to erythromycin, rifampicin, and streptomycin with 38±2.1, 26±1.6, 20±0.6 and 15±0.4 mm of the zone of inhibition against Staphylococcus aureus, Bacillus subtilis, Escherichia coli and Pseudomonas aeruginosa, respectively. The antibacterial activity of isolated glycosyl flavonoids was expressed as percent of ciprofloxacin standard to normalize the activity against a spectrum of microorganisms. The growth inhibition in terms of percent standard by O-glycosyl flavanone was 40.21±2.1, 17.76±1.3, 17.00±1.1 and 20.66±0.9 %; O-glycosyl flavone was 50.26±2.5, 57.53±2.1, 25.00±1.6 and 33.33±0.8 % and C-glycosyl flavone was 80.94±2.5, 73.61±1.5, 58±1.6 and 47.33±1.7 % against S. aureus, B. subtilis, E. coli and P. aeruginosa, respectively at 25µg/ml concentration (fig. 2b).
Antifungal activity of isolated glycosyl flavonoids was evaluated at different concentrations ranging from 5-25µg/ml and expressed as % of linear mycelial growth reduction (table 3). Significantly high growth inhibition was observed at 25µg/ml (Fig.3a). Graphical representation of results indicate that O-glycosyl flavanone inhibited the linear growth of R. oryzaeand A. niger by 45±0.5 and 60±0.4%; O-glycosyl flavone inhibited 41±1.7 and 43±0.9%; C-glycosyl flavone inhibited 83±0.4 and 70±0.9%, and clotrimazole inhibited 95±0.7 and 76±0.1% control, respectively after 7 d growth on PDA medium (fig. 3b).
Table 1: Antibacterial activity of O-glycosyl flavanone, O-glycosyl flavone, and C-glycosyl flavone against bacterial strains of Staphylococcus aureus, Bacillus subtilis, Escherichia coli and Pseudomonas aeruginosa at concentration of 5-25μg/ml
Compounds |
Concentration (µg/ml) |
Zone of inhibition (mm) |
|||
S. aureus |
B. subtilis |
E. coli |
P. aeruginosa |
||
O-glycosyl flavonone |
5 |
02±0.1 |
01±0.1 |
01±0.1 |
ND |
10 |
04±0.2 |
02±0.1 |
02±0.2 |
01±0.1 |
|
15 |
07±0.4 |
04±0.1 |
02±0.2 |
02±0.1 |
|
20 |
10±0.8 |
06±0.2 |
04±0.1 |
03±0.2 |
|
25 |
13±1.2 |
08±0.4 |
06±0.2 |
04±0.3 |
|
O-glycosyl flavone |
5 |
05±0.2 |
02±0.1 |
03±0.1 |
ND |
10 |
09±0.3 |
05±0.2 |
03±0.1 |
01±0.1 |
|
15 |
14±0.5 |
09±0.4 |
05±0.2 |
02±0.1 |
|
20 |
17±1.1 |
13±0.6 |
07±0.2 |
03±0.2 |
|
25 |
21±1.6 |
16±1.2 |
09±0.6 |
05±0.4 |
|
C-glycosyl flavone |
5 |
06±0.3 |
04±0.1 |
01±0.1 |
01±0.1 |
10 |
11±0.5 |
07±0.3 |
05±0.2 |
02±0.1 |
|
15 |
17±1.1 |
11±0.4 |
07±0.2 |
04±0.1 |
|
20 |
24±1.4 |
15±0.7 |
09±0.5 |
06±0.2 |
|
25 |
30±1.9 |
22±1.1 |
12±0.8 |
08±0.3 |
|
Values are mean+SD [n=3]
Table 2: Antibacterial activity of ciprofloxacin, erythromycin, rifampicin and streptomycin against bacterial strains of S. aureus, B. subtilis E. coli and P. aeruginosa at concentration of 2-10μg/ml
Antibiotic |
Concentration (µg/ml) |
Zone of inhibition (mm) |
|||
S. aureus |
B. subtilis |
E. coli |
P. aeruginosa |
||
Ciprofloxacin |
2 |
05±0.2 |
04±0.3 |
02±0.1 |
01±0.1 |
4 |
12±0.2 |
10±0.1 |
07±0.2 |
05±0.3 |
|
6 |
17±0.4 |
16±0.1 |
10±0.3 |
09±0.2 |
|
8 |
21±0.8 |
20±0.2 |
14±0.1 |
11±0.4 |
|
10 |
38±2.1 |
26±1.6 |
20±0.6 |
15±0.4 |
|
Erythromycin |
2 |
02±0.2 |
02±0.1 |
03±0.1 |
ND |
4 |
05±0.3 |
06±0.2 |
05±0.1 |
04±0.1 |
|
6 |
11±0.5 |
09±0.4 |
10±0.2 |
10±0.1 |
|
8 |
17±1.1 |
13±0.6 |
14±0.2 |
13±0.2 |
|
10 |
20±0.2 |
16±1.2 |
19±0.6 |
15±0.4 |
|
Rifampicin |
2 |
02±0.3 |
02±0.1 |
01±0.1 |
01±0.1 |
4 |
11±0.5 |
07±0.3 |
05±0.2 |
08±0.1 |
|
6 |
17±1.1 |
11±0.4 |
10±0.2 |
10±0.1 |
|
8 |
19±1.4 |
15±0.7 |
15±0.5 |
13±0.2 |
|
10 |
21±1.0 |
22±1.1 |
19±0.8 |
18±0.3 |
|
Streptomycin |
2 |
01±0.3 |
02±0.1 |
03±0.1 |
01±0.1 |
4 |
06±0.2 |
05±0.1 |
06±0.2 |
07±0.3 |
|
6 |
10±0.5 |
09±0.4 |
09±0.2 |
10±0.1 |
|
8 |
13±1.1 |
12±0.6 |
13±0.2 |
14±0.2 |
|
10 |
19±0.8 |
18±0.2 |
17±0.1 |
18±0.4 |
|
Values are mean+SD [n=3]
Antimicrobial susceptibility of isolated glycosyl flavonoids was determined in terms of minimum inhibitory concentration (MIC), minimum bactericidal concentration (MBC) or MFC. The results showed that MIC of O-glycosyl flavanone was 3.12±0.01, 3.12±0.02, 6.25±0.04 and 12.5±0.04 µg/ml; O-glycosyl flavone was 3.12±0.03, 1.56±0.02, 6.25±0.05 and 12.5±0.06 µg/ml; C-glycosyl flavone was 1.56±0.02, 0.75±0.01, 3.12±0.02 and 6.25±0.05 µg/ml and ciprofloxacin was 0.6±0.01, 1.25±0.02, 2.5±0.05 and 2.5±0.06µg/ml against S. aureus, B. subtilis, E. coli and P. aeruginosa, respectively (fig. 4a). The MBC of O-glycosyl flavanone was 12.5±0.09, 12.5±0.04, 35±1.12 and 56±1.56 µg/ml, O-glycosyl flavone was 12.5±0.06, 6.25±0.02, 30±1.40 and 60±2.56 µg/ml, C-glycosyl flavone was 3.12±0.02, 1.56±0.01, 12.5±0.04 and 25±0.07 µg/ml and ciprofloxacin was 1.25±0.02, 2.5±0.01, 5±0.04 and 5±0.03 µg/ml against S. aureus, B. subtilis, E. coli and P. aeruginosa, respectively (fig. 4b). The MIC index (MBC/MIC) of O-glycosyl flavanone was 4.0±0.02, 4.0±0.02, 5.6±0.01 and 4.4±0.01, O-glycosyl flavone was 4.06±0.01, 4.05±0.02,4.8±0.05 and 4.8±0.04, C-glycosyl flavone was 2.0±0.01, 2.0±0.01, 4.0±0.03 and 4.0±0.02 and ciprofloxacin was 2.0±0.01, 2.0±0.01, 2.08±0.03 and 2.1±0.02 against B. subtilis, S. aureus, E. coli,and P. aeruginosa, respectively.
Minimum inhibitory concentration (MIC) of O-glycosyl flavanone was 3.12±0.02 and 6.25±0.02 µg/ml; O-glycosyl flavone was 1.56±0.02 and 3.12±0.02 µg/ml; C-glycosyl flavone was 0.75±0.01 and 1.56±0.02 µg/ml and clotrimazole was 0.62±0.03 and 1.25±0.03 µg/ml against R. oryzae and A. niger, respectively (fig. 4c).The MFC values of O-glycosyl flavanone was 6.25±0.05 and 12.5±0.09µg/ml; O-glycosyl flavone was 3.12±0.05 and 6.25±0.13µg/ml; C-glycosyl flavone was 1.56±0.06 and 3.12±0.15µg/ml and clotrimazole was 1.25±0.04 and 2.5±0.12 µg/ml against R. oryzae and A. niger, respectively (fig. 4e). These results indicate that C-glycosyl flavone is effective against R. oryzae and A. niger compared to other glycosyl flavonoids. The results of MIC index indicate C-glycosyl flavone act as fungicidal agents (<4) against R. oryzae and A. niger.
Synergism of C-glycosyl flavone with antibiotics
Fractional inhibitory concentration (FIC) is one of the good approaches to determine the synergistic action of C-glycosyl flavone with antibiotics [13]. In the present study, the potential synergistic activity of C-glycosyl flavone in the terms of FIC index on ciprofloxacin against four bacteria species was evaluated. The FIC index value of C-glycosyl flavone was 0.5 against B. subtilis and 0.3 against S. aureus. Further, the FIC index of C-glycosyl flavone on clotrimazole against R. oryzae and A. niger was 0.3 and 0.48, respectively (table 4). These results indicate that C-glycosyl flavone showed a synergistic effect on ciprofloxacin against S. aureus and B. subtilis and clothrimozole against R. oryzae and A. niger.
Fig. 2: Antimicrobial activity of isolated flavonoids against representative strains of bacteria. (a) Antibacterial activity of O-glycosyl flavanone, O-glycosyl flavone and C-glycosyl flavone was determined using disc diffusion method against Staphylococcus aureus, Bacillus subtilis, Escherichia coli and Pseudomonas aeruginosa at the concentration of (25μg/ml). The results were expressed as a zone of inhibition in mm. (b) Bacterial growth inhibition by O-glycosyl flavanone, O-glycosyl flavone, and C-glycosyl flavone in terms of percent ciprofloxacin standard (10 μg/ml)
Values are mean+SD [n=3]
Table 3: Antifungal activity of O-glycosyl flavanone, O-glycosyl flavone and C-glycosyl flavone at concentration of 5-25μg/ml and clotrimazole (2-10μg/ml) on fungal strains of Rhizopus oryzae and Aspergillus niger
Compound/antibiotic |
Concentration (µg/ml) |
% of linear mycelium growth reduction |
|
R. oryzae |
A. niger |
||
O-glycosyl flavonone |
5 |
12±0.1 |
15±0.1 |
10 |
19±0.2 |
29±0.1 |
|
15 |
27±0.4 |
41±0.1 |
|
20 |
31±0.8 |
51±0.2 |
|
25 |
45±0.5 |
60±0.4 |
|
O-glycosyl flavone |
5 |
10±0.2 |
12±0.1 |
10 |
17±0.3 |
19±0.2 |
|
15 |
21±0.5 |
27±0.4 |
|
20 |
34±1.1 |
30±0.6 |
|
25 |
41±1.7 |
43±0.9 |
|
5 |
26±0.3 |
20±0.1 |
|
C-glycosyl flavone |
5 |
26±0.3 |
20±0.1 |
10 |
34±0.5 |
29±0.3 |
|
15 |
47±1.1 |
41±0.4 |
|
20 |
64±1.4 |
59±0.7 |
|
25 |
83±0.4 |
70±0.9 |
|
Clotrimazole |
2 |
31±0.8 |
29±0.1 |
4 |
51±0.2 |
41±0.1 |
|
6 |
69±0.7 |
56±0.2 |
|
8 |
82±0.4 |
66±1.4 |
|
10 |
95±0.7 |
76±0.1 |
|
Values are mean+SD [n=3]

Fig. 3: Antifungal activity of isolated flavonoids against representative strains of fungi. (a) Antifungal activity of O-glycosyl flavanone, O-glycosyl flavone, C-glycosyl flavone (25μg/ml) and clotrimazole (10μg/ml) against R. oryzae and A. niger. (b) Percent of mycelial growth reduction by O-glycosyl flavanone, O-glycosyl flavone, C-glycosyl flavone and standard clotrimazole
Values are mean+SD [n=3]

Fig. 4: Effect of isolated glycosyl flavonoids on microbial growth. (a) Minimum inhibitory concentration (MIC) of O-glycosyl flavanone, O-glycosyl flavone, C-glycosyl flavone and ciprofloxacin against S. aureus, B. subtilis E. coli and P. aeruginosa in terms μg/ml. (b) Minimum bactericidal concentration (MBC) of isolated glycosyl flavonoids and ciprofloxacin against representative bacteria in terms of μg/ml. (c) Minimum inhibitory concentration (MIC) of O-glycosyl flavanone, O-glycosyl flavone, C-glycosyl flavone and clotrimazole against R. oryzae and A. niger in terms μg/ml. (d) Minimum fungicidal concentration (MFC) of O-glycosyl flavanone, O-glycosyl flavone, C-glycosyl flavone and clotrimazole against R. oryzae and A. niger in terms μg/ml
Values are mean+SD [n=3]
Table 4: Fractional inhibitory concentration (FIC) of C-glycosyl flavone with ciprofloxacin on S. aureus and B. subtilis and clotrimazole on R. oryzae and A. niger in μg/ml. FIC index ≤ 0.5–synergism,>0.5–4.0–indifference,>4.0–antagonism
Organisms |
FIC index of C-glycosyl flavone |
|
Ciprofloxacin |
Clothrimozole |
|
S. aureus |
0.3 |
- |
B. subtilis |
0.5 |
- |
R. oryzae |
- |
0.3 |
A. niger |
- |
0.48 |
The MIC and MBC are used to indicate antimicrobial activity at high concentrations. However, sub-inhibitory antimicrobial concentrations, the lowest antimicrobial concentration resulting in a 90% decrease in population compared to control is clinically important. In this study, it was found that sub-inhibitory concentrations, 1/8 and 1/4 MIC of C-glycosyl flavone enhanced the antibacterial activity of ciprofloxacin against S. aureus and B. subtilis up to 4 and 8 folds, respectively. Further, at 1/16 and 1/8 MIC enhanced the antifungal activity of clotrimazole up to 7 and 12 folds against R. oryzae and A. niger. These results indicate that C-glycosyl flavone was the potent antimicrobial compound which is responsible for synergistic effects (table 5).
Table 5: Sub-inhibitory concentrations of C-glycosyl flavone with ciprofloxacin on Staphylococcus aureus, Bacillus subtilis, Escherichia coli and Pseudomonas aeruginosa and clotrimazole on Rhizopus oryzae and Aspergillus niger in μg/ml
Test organism |
Sub-inhibitory concentrations of C-glycosyl flavone (µg/ml) |
Antimicrobial activity (fold change) |
|
ciprofloxacin |
clothrimazole |
||
S. aureus |
1/8 |
- |
8 |
B. subtilis |
1/4 |
- |
4 |
R. oryzae |
- |
1/16 |
12 |
A. niger |
- |
1/8 |
7 |
Values are mean+SD [n=3]
The synergistic effect of C-glycosyl flavone on antibiotic-induced cytotoxicity
To study a mode of action of isolated C-glycosyl flavone or combination with antibiotics, cytotoxic activity was determined as the preliminary study using MTT assay. The results showed that C-glycosyl flavone or ciprofloxacin or combination exhibited 48, 56 and 89% cytotoxicity against S. aureus whereas 56, 63 and 91% against B. subtilis (fig. 5a). However, C-glycosyl flavone or clotrimazole or combination exhibited 28, 36 and 49% cytotoxicity against R. oryzae whereas 26, 23 and 41% against A. niger (fig. 5b).
Propidium iodide (PI) staining has been historically interpreted as an indicative of dead cells in either eukaryotes or prokaryotes. In the present study, propodium iodide staining was used to evaluate the synergistic effect of C-glycosyl flavone on ciprofloxacin-induced bacterial cell death or clotrimazole induced fungal cell death. The results indicate that the propidium iodide positive S. aureus cells with C-glycosyl flavone or ciprofloxacin or combination were 36, 52 and 86%, respectively, whereas B. subtilis were 34, 48 and 82%, respectively (fig. 5c). The results also indicate that the propidium iodide stained R. oryzae with C-glycosyl flavone or ciprofloxacin or combination were 26, 32 and 46%, respectively, whereas A. niger was 24, 28 and 32%, respectively (fig. 5d).
To further determine whether C-glycosyl flavone promoting DNA fragmentation in test microorganisms, we performed terminal deoxynucleotidyl transferase dUTP nick-end labeling (TUNEL) on antibiotic-treated cells with modifications. The results indicate that the tunel positive S. aureus cells with C-glycosyl flavone or ciprofloxacin or combination were 46, 62 and 82%, whereas B. subtilis was 43, 58 and 80% (fig. 5e). The results also showed that the tunel positive R. oryzae with C-glycosyl flavone or clotrimazole or combination were 26, 36 and 51%, whereas A. niger was 23, 38 and 48% (fig. 5f).
To study the effect of C-glycosyl flavone on antibiotic-induced cytoplasm membrane damage, potassium leakage was measured. From the results, it is apparent that potassium leakage with C-glycosyl flavone was 24.5 ppm in S. aureus and 21.4 ppm in B. subtilis. Whereas with ciprofloxacin was 32.6 ppm in S. aureus and 30.4 ppm in B. subtilis. However, with C-glycosyl flavone-antibiotic combination, the potassium leakage was 42.4 and 39.6 ppm in S. aureus and B. subtilis, respectively. The potassium leakage with C-glycosyl flavone was 14.5 ppm in R. oryzae and 11.4 ppm in A. niger. Whereas with clotrimazole was 22.6 ppm in R. oryzae and 18.4 ppm in A. niger. However, with C-glycosyl flavone-antibiotic combination, the potassium leakage was 32.4 and 35.6 ppm in R. oryzae and A. niger, respectively.
DISCUSSION
Medicinal plants are the richest source of potential antimicrobial agents [13]. The exploitation of pure antimicrobial agents has several advantages, including reproducibility, accuracy and also useful in the synthesis of synthetic molecules, structural modifications and rationalization of the mechanism of action [12]. Our previous study has demonstrated that methanolic extract of U. indica bulb exhibited good antioxidant activity compared to other solvent extracts. In the present study, three homogeneously pure compounds were isolated. One compound exhibited major UV peak at 256 nm, the second one at the 348 nm and third one at 271 nm. The absorption maxima at 257, 349 and 270 nm were reported as characteristics of flavonoid compounds [8]. A phytochemical study using qualitative tests with specific reagent indicates that all the three compounds are positive for flavonoids (Data not shown). These results suggested that isolated compounds are flavonoids.
Assignments and confirmation of flavone or flavonone structure were done based on the complicated flavone [13]C NMR data. Accordingly, the structure of compound-1 was identified as 5, 4'-di hydroxyl-3'-methoxy-7-o-(α-L-rhamnosyl-(1'''-6'')-β-D-glucopyranosyl) flavanone (C28H34O15) with molecular weight of 610, compound-2 as 5, 4'-dihydroxy-3'-methoxy-7-O-β-D-glucopyranosyl flavone (C22H24O11) with moleclular weight of 464 and compound-3 as 5, 7-dihydroxy-2-[4'-hydroxy-3'-(methoxy-methyl) phenyl]-6-C-β-glucopyranosyl flavone (C23H24 011) with molecular weight of 493.
The emergence of drug resistance is one of the worldwide clinical threats. Extensive use of antibiotics for the treatment of microbial infections has led to the emanation and spread of resistant strains. In the last few years, research on the discovery of new antibiotics or synergistic natural compounds has been conducted. The present study demonstrated that the isolated glycosyl flavonoids exhibited significant antibacterial activity against gram-positive bacteria S. aureus and B. subtilis and less activity against gram-negative bacteria E. coli and P. aeruginosa. Among the isolated compounds, C-glycosyl flavone exhibited strong antibacterial activity. Significantly high growth inhibition of gram positive bacteria may be due to the absence of an extra outer membrane, which may be permeable to the glycosyl flavonoids. These results appear to correlate with earlier claims of medicinal and antimicrobial uses of U. indica [4].Recently, the antibacterial activity of the crude methanolic extract of U. indica bulb against E. coli, S. aureus and P. aeruginosa was reported [3].

Fig. 5: Synergistic effect of C-glycosyl flavone on antibiotic induced cytotoxicity. Cytotoxicity effect of C-glycosyl flavone or ciprofloxacin or combination on S. aureus and B. subtilis (a) and clotrimazole or combination on R. oryzae and A. niger (b) by MTT assay. The results were expressed in terms of % of cytotoxicity. Effect of C-glycosyl flavone or ciprofloxacin or combination on cell death of S. aureus and B. subtilis (c) and clotrimazole or combination on R. oryzae and A. niger cell death (d) by as determined by PropidiumIodide staining. The results were expressed in terms of % of PI positive cells. Cytotoxicity effect of C-glycosyl flavone or ciprofloxacin or combination on apoptosis like cell death of S. aureus and B. subtilis (e) and clotrimazole or combination on R. oryzae and A. niger (f) as determined by TUNEL assay. The results were expressed in terms of % of TUNEL positive cells. Effect of C-glycosyl flavone or ciprofloxacin or combination on cytoplasm membrane damage of S. aureus and B. subtilis (g) and clotrimazole or combination on R. oryzae and A. niger
Values are mean+SD [n=3]
Antibacterial efficacy of the natural compounds was generally evaluated in terms of minimum inhibitory concentration (MIC) and minimum bactericidal concentration (MBC). In the present study, isolated O-glycosyl flavanone, O-glycosyl flavone and C-glycosyl flavone showed significantly lower MIC and MBC values against gram-positive bacteria (B. subtilis, and S. aureus) compared to gram-negative bacteria (E. coli and P. aurosinosa), this may be fact that different bacteria are inhibited by phytochemical compounds with different mechanisms[9]. According to NCCLS protocol, MIC index indicates the bactericidal or bacteriostatic mechanism of action. Bactericidal compounds kill the microorganisms, whereas as bacteriostatic compounds inhibit cell division. If the MIC index is ≤ 4, the compound was considered as bactericidal, whereas if>4 and<32, the compound was considered as bacteriostatic. The results of the present study reveal that isolated C-glycosyl flavone have strong bactericidal activity against B. subtilis and S. aureus. Generally, bactericidal compounds are more potent than bacteriostatic compounds. It is well established that bactericidal activity is an important determinant of clinical outcome [13]. Therefore, the present results suggest that isolated C-glycosyl flavone of U. indica can be used in bactericidal therapy.
Various antimicrobials at sub-inhibitory concentrations have been reported to inhibit the rate of bacterial growth in vitro. The number of infecting organisms is important in the clinical outcome of infection; a 90% reduction in bacterial population at sub-inhibitory antimicrobial concentrations could have important clinical consequences [24]. In this study, it was found that at sub-inhibitory concentrations (1/8 and1/4MIC) of C-glycosyl flavone enhanced the antibacterial activity of ciprofloxacin against S. aureus and B. subtilis up to 8 and 4 folds, respectively by reducing the minimum inhibitory concentration of antibiotic required to inhibit the growth of bacteria.
The incidences of fungal infection are increasing significantly in the past 25 y and are responsible for the majority of invasive and non-invasive fungal infections. To expand the spectrum of antibacterial activity of isolated glycosyl flavonoids, the antifungal activity against most common fungi was also conducted. This study demonstrated the highest potency of C-glycosyl flavone against R. oryzae and A. niger in terms of low minimum inhibitory (MIC) and minimum fungicidal concentrations (MFC). The results of MIC index indicate that isolated C-glycosyl flavone is a potent fungicidal agent (≤ 2) against all tested fungi.
For the past several years, microbiologists have conducted laboratory experiments on various bacteria and fungi with isolated glycosyl flavonoids from medicinal plants to enhance its spectrum of action [20]. Reports stated that medicinal plant compounds with MIC value less than 1 mg/ml are clinically relevant. This may be true regarding C-glycosyl flavone isolated from U. indica, because it showed significant antimicrobial activity with greater synergistic activity [19].
Drug synergism between known antibiotics and glycosyl flavonoids from medicinal plants is an innovative concept and beneficial for understating the mechanism of drug resistance. Mechanism of synergy is also fundamental for the development of pharmacological agents against drug resistant microbial infections. The most effective approach to overcome the microbial resistance is the use of natural synergistic antimicrobial with synthetic agents [9].
The FIC index is frequently used to determine the interaction between antimicrobial compounds and antibiotics. The combination of antibiotics is considered as synergistic if the FIC is ≤0.5 or as partial synergistic if 0.5<FIC ≤ 0.75 or as no effect if 0.75<FIC ≤ 2 and as antagonistic when ΣFIC is>2. However, drug-drug interactions are considered synergistic if the FIC index is less than 1.0; additive if the FIC is equal to 1.0; less-than-additive if the FIC index is greater than 1.0 for fungi [16]. Accordingly, the isolated C-glycosyl flavone exhibited significant synergistic interaction with ciprofloxacin against S. aureus and B. subtilis and clotrimazole against R. oryzae and A. niger.
The significance of theseobservations lies in the fact that antibiotics arecausing the development of drug resistance in microbes therebylimiting the clinical success of antibiotic therapy. Recent reports showed that combination therapy is a superior modality and that naturally occurring dietary supplements with known antibiotics could be used in combination compound therapy to reduce the drug resistance [11].
Drug susceptibility testing of microorganisms by conventional methods is complicated and time-consuming. The MTT assay is a simple, inexpensive and easily interpretable by the naked eye. It is a rapid screening method used for identification of antimicrobial agents [20]. It was originally introduced by Mossman as a quantitative measure of mammalian cell proliferation and was subsequently used to detect the viability of bacteria under adverse conditions. MTT is a yellow tetrazolium salt that is converted to a blue formazan by dehydrogenases of a living cell. It is based on the principle that the amount of formazan produced is directly proportional to the number of live cells. It could also potentially be used as a simple screening method for evaluating drug synergism between the antimicrobial agents. The most common infections are caused by gram-negative organisms. However, serious infections have become more predominant in the past decade due to gram-positive. The results of the present study indicate that isolated C-glycosyl flavone significantly enhanced ciprofloxacin-induced cytotoxicity against gram-positive bacteria S. aureus and B. subtilis and clotrimazole against R. oryzae and A. niger. These results correlated with of antimicrobial activity and synergistic efficacy of C-glycosyl flavone.
Apoptosis is physiologically programmed cell death involves the biological regulation of vital activities of cells. Recent studies have demonstrated the evidence of apoptosis in bacteria as a function of antibacterial drugs [12]. Flavonoid compounds have been known for their ability to effect cytoplasmic membrane permeability consequently resulting in leakage of cellular constituents like nucleic acids, proteins and inorganic ions such as phosphate and potassium [17]. Potassium leakage is a measure of membrane damage in microorganisms. High potassium leakage from C-glycosyl flavone-ciprofloxacin combination than the C-glycosyl flavone and ciprofloxacin alone is indicating the additive effect of C-glycosyl flavone on ciprofloxacin-induced bacterial membrane damage. In addition to membrane damage, apoptosis-like cell death in bacteria is also characterized by DNA fragmentation. In our investigation, significantly increased tunel positive cells was observed with the of ciprofloxacin and C-glycosyl flavone treatment in both S. aureus and B. subtilis compared to individual treatments, indicating the additive effect of C-glycosyl flavone on ciprofloxacin-induced apoptosis. C-glycosyl flavone also showed but less addictive clotrimazole effect on induced apoptosis in fungi, R. oryzae and A. niger, compared to tested bacteria.
In conclusion, our data might provide a rational basis for the use of C-glycosyl flavone from U. indica in clinical and throw light on the development of the novel antibacterial drugs.
ACKNOWLEDGEMENT
We thank authorities of GITAM University for continuous support and encouragement. We also thank authorities of Raghu Degree and P. G college for the providing facility for carrying out this work.
CONFLICT OF INTERESTS
We wish to confirm that there are no known conflicts of interest associated with this publication and there has been no significant financial support for this work that could have influenced its outcome.
REFERENCES
- Levy SB, Marshall B. Antibacterial resistance worldwide, causes challenges and responses. Nat Med 2004;10 Suppl 1:122-9.
- Hancock EW. Mechanisms of action of newer antibiotics for Gram-positive pathogens. Lancet Infect Dis 2005;5:209-18.
- Kohanski MA, Dwyer DJ, Hayete B, Lawrence CA, Collins JJ. A common mechanism of cellular death induced by bactericidal antibiotics. Cell 2007;130:797-810.
- Nagoshi C, Shiota S, Kuroda T, Yoshida T, Kariyama R, Tsuchiya T. Synergistic effect of gingerol and aminoglycosides against vancomycin-resistant enterococci (VRE). Biol Pharm Bull 2006:29:443-7.
- Fuchs Y, Steller H. Programmed cell death in animal development and disease. Cell 2011;147:742-58.
- Dwyer DJ, Kohanski MA, Collins JJ. Role of reactive oxygen species in antibiotic action and resistance. Curr Opin Microbiol 2009;12:482-9.
- Dwyer DJ, Camacho DM, Kohanski MA, Callura JM, Collins JJ. Antibiotic-induced bacterial cell death exhibits physiological and biochemical hallmarks of apoptosis. Mol Cell 2012;46:561-72.
- Shirazi F, Pontikos MA, Walsh TJ, Albert N, Lewis RE, Kontoyiannis DP. Hyperthermia sensitizes Rhizopus oryzae to posaconazole and itraconazole action through apoptosis. Antimicrob Agents Chemother 2013;57:4360-8.
- Anandhi D, Srinivasan PT, Praveen GK, Jagatheesh S. DNA fragmentation induced by the glycosides and flavonoids from C. coriaria. Int J Curr Microbiol Appl Sci 2014;3:666-73.
- Sahoo S, Rao KK, Suraishkumar GK. Reactive oxygen species induced by shear stress mediate cell death in Bacillus subtilis. Biotechnol Bioeng 2006;94:118-27.
- Yu Tanouchi, Anna Jisu Lee, Hannah Meredith, Lingchong You. Programmed cell death in bacteria and implications for antibiotic therapy. Trends Microbiol 2013;21:265–70.
- Hasegawa T, Tanaka A, Hosoda A, Takano F, Ohta T. Antioxidant C-glycosyl flavones from the leaves of Sasa kurilensis var. gigantea. Phytochemistry 2008;69:1419-24.
- Jianbo Xiao. Phytochemicals in food and nutrition. Crit Rev Food Sci Nutr 2015. Epub ahead of print. [Article in Press]
- Cushnie TP, Lamb AJ. Antimicrobial activity of flavonoids. Int J Antimicrob Agents 2005;26:343-56.
- Shibata H, Kondo K, Katsuyama R, Kawazoe K, Sato Y, Murakami K, et al. Alkyl gallates, intensifiers of beta-lactam susceptibility in methicillin-resistant Staphylococcus aureus. Antimicrob Agents Chemother 2005;49:549-55.
- Muhammad Usman Amin, Muhammad Khurram, Baharullah Khattak, Jafar Khan. Antibiotic additive and synergistic action of rutin, morin and quercetin against methicillin resistant S. aureus. BMC Complementary Altern Med 2015 15:59.
- Deb, DB, Dasgupta S. Studies on Indian squill Urginea indica. Q J Crude Drug Res 1976;14:49-60.
- Benkablia N. Antimicrobial activity of essential oil extracts of various Onions and garlic. Lebensm-WISS-U-Technol 2004:373-5.
- Ganesh babu bevara. Analysis of antioxidant and anticancer potentials of Urginea indica, an endangered medicinal plant. J Parasitol Res 2012;5:4921-8.
- Panduranga murthy G. Phytochemical analysis, in vitro anti-bacterial and antioxidant activities of wild onion sps. Int J Pharm Biosci 2011;3:230-8.
- Styers D, Sheehan DJ, Hogan P, Sahm DF. Laboratory-based surveillance of current antimicrobial resistance patterns and trends among Staphylococcus aureus, status in the United states. Ann Clin Microbiol Antimicrob 2006;5:2-5.
- Tyber H, Zanina N, Neffati M. cytotoxic and antibacterial activities of leaf extracts of Astragalus gombiformis pommel (Fabaceae) growing wild in Tunisia. Turk J Biol 2012;36:53-8.
- Haggag WM, El-khair HA. Application of some natural compounds for management of potato late and early blights. J Food Agric Environ 2007;5:157-63.
- Jaganathan SK, Mazumdar A, Mondhe D, Mandal M. Apoptotic effect of eugenol in human colon cancer cell lines. Cell Biol Int 2011;35:607-15.
- Parekh J, Chanda S. In vitro antibacterial activity of the crude methanol extract of Woodfordia fructicosa kurz flower (Lythraceae). Braz J Microbiol 2007;38:204-7.